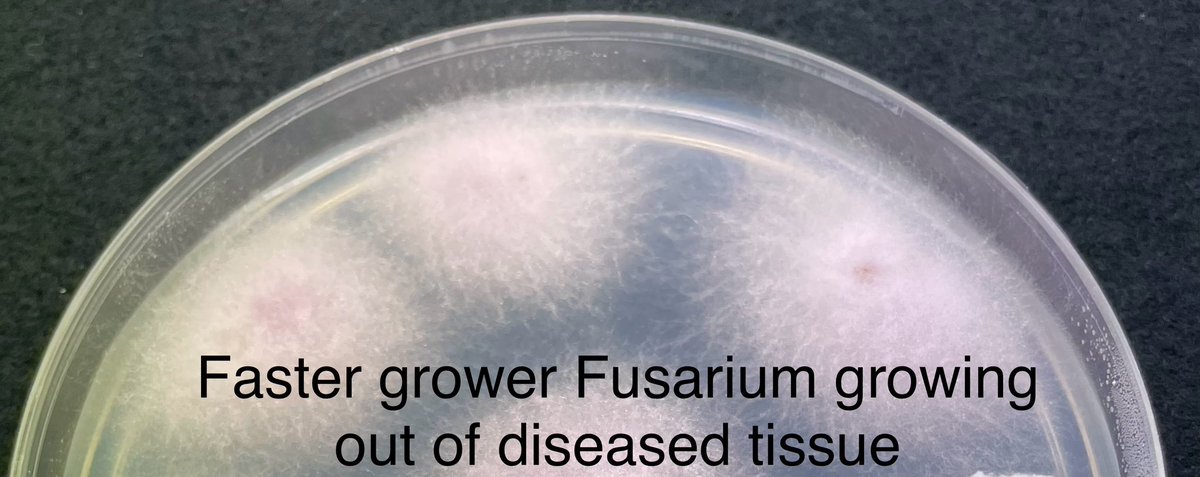
VERT ALERT 🚨 
Our <a href="/CottonInfoAust/">CottonInfo</a> <a href="/LambethEmma/">Emma Lambeth</a> spotted this in the Namoi last week. Early symptoms of leaf yellowing and wilting could be mis-ID between #Fusarium &amp; #Verticillium in the fields, but they are quite distinct in cultures. Get it ID correctly is crucial.

Janelle Montgomery
@nellmonth2o
ID: 2903313318
18-11-2014 06:50:07
131 Tweet
409 Takipçi
216 Takip Edilen



Want to keep up to date with ways to reduce spray drift in your region and protect the health of your family and community? Visit sos-nsw.com #StopOffTargetSpraying SOS Macquarie Valley SOS Balonne SOS Gwydir CWFS

Interested in what Mick O'Brien from Armatree is doing to optimise his spray operations? Take a look...youtu.be/qiuxxbV6IfI #SOS_NSW #StopOffTargetSpraying SOS Macquarie Valley SOS Balonne SOS Gwydir CWFS GRDC


Worryingly, farmers in Aus have a 60% higher death rate from melanoma compared to the general population. Which is why we have partnered with MSCAN to offer FREE SKIN CHECKS to delegates of the Cotton Conference. Book now - bit.ly/3A8jESZ Cotton Australia

The fantastic Carolyn Alchin has been working with @QldFarmers to create the Careers in Agriculture digital magazine. They've got a launch on the 24th of October:eventbrite.com.au/e/careers-in-a… accell-research.com







📷PHOTO CALL FOR 2024 WATER CALENDAR📷 Got a cracker photo of a beautifully irrigated crop in flower? What about a photo of Mum starting the siphons after Christmas dinner? We'd love to see it! 📷Send submissions in by October 15 to [email protected] for consideration!


SOS NSW, Industry and @NSWEPA are working together to deliver 3 spray drift projects this season. We can manage spray drift better – together! Contact your local SOS group and stay informed 👉 sos-nsw.com/sos-communitie… SOS Gwydir SOS Macquarie Valley IREC mungindicropping #SOS_NSW


In the past 12 months there was 107,000 ha affected by spray drift equating to $100M of damage to cotton crops alone. Report spray drift on your property. 👉 131 555 👉 [email protected] SOS Macquarie Valley IREC SOS Gwydir


VERT ALERT 🚨 Our CottonInfo Emma Lambeth spotted this in the Namoi last week. Early symptoms of leaf yellowing and wilting could be mis-ID between #Fusarium & #Verticillium in the fields, but they are quite distinct in cultures. Get it ID correctly is crucial.